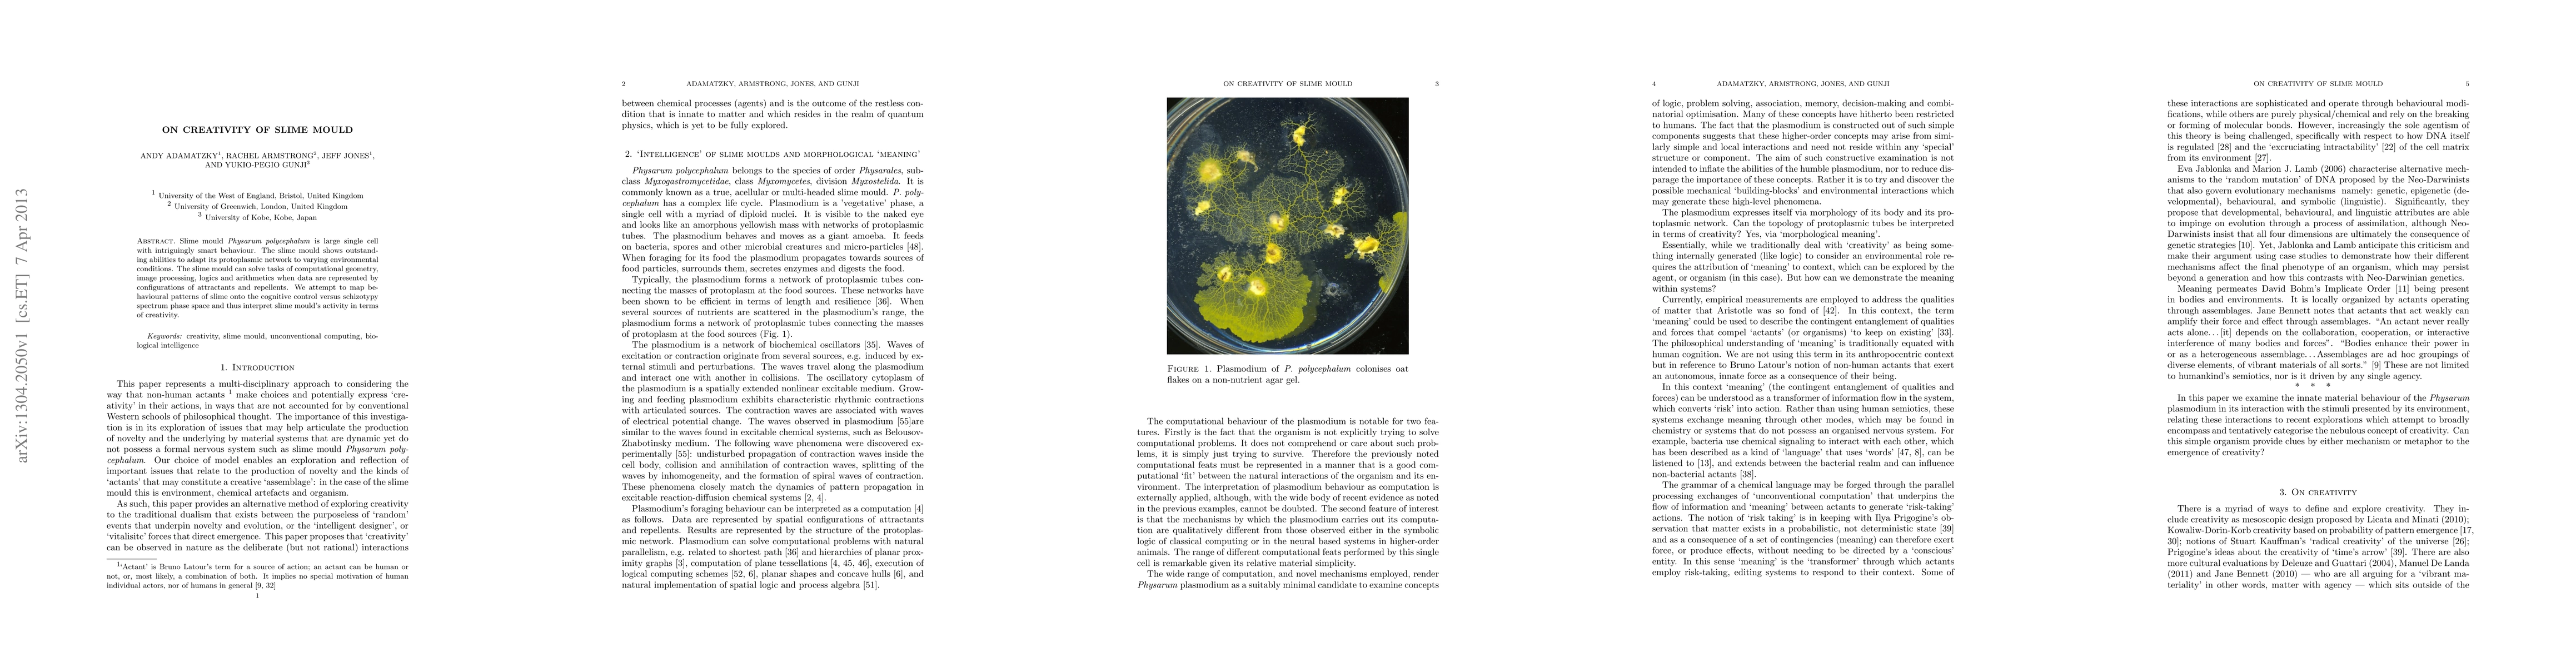

AI Quick Summary
This paper explores the adaptive and problem-solving abilities of the slime mould Physarum polycephalum, demonstrating its capacity to tackle computational tasks through environmental interactions. The study aims to interpret the slime mould's behavior in terms of creativity by mapping its patterns to cognitive control and schizotypy spectrum.
Abstract
Slime mould Physarum polycephalum is large single cell with intriguingly smart behaviour. The slime mould shows outstanding abilities to adapt its protoplasmic network to varying environmental conditions. The slime mould can solve tasks of computational geometry, image processing, logics and arithmetics when data are represented by configurations of attractants and repellents. We attempt to map behavioural patterns of slime onto the cognitive control versus schizotypy spectrum phase space and thus interpret slime mould's activity in terms of creativity.
AI Key Findings
Get AI-generated insights about this paper's methodology, results, and significance.
Paper Details
How to Cite This Paper
@article{anon2013on,
title = {On Creativity of Slime Mould},
year = {2013},
eprint = {1304.2050},
archivePrefix = {arXiv},
primaryClass = {cs.ET},
doi = {10.1080/03081079.2013.776206},
}(2013). On Creativity of Slime Mould. arXiv. https://doi.org/10.1080/03081079.2013.776206"On Creativity of Slime Mould." arXiv, 2013, doi.org/10.1080/03081079.2013.776206.PDF Preview
Key Terms
Citation Network
Current paper (gray), citations (green), references (blue)
Display is limited for performance on very large graphs.
Similar Papers
Found 4 papers| Title | Authors | Year | Actions |
|---|
Comments (0)